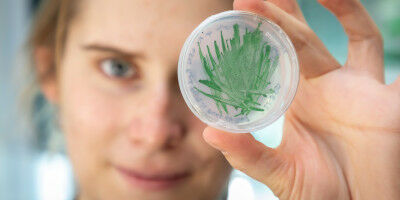
Cyanobacteria as 'green' catalysts in biotechnology

news
Chemistry
Results 1441 - 1460 of 3957.
Chemistry - Environment - 23.10.2020
Students find sweet positives in carbon-negative hydrogen
Final-year chemical engineering students at The University of Queensland are investigating how sugarcane can be used as a clean energy source to create hydrogen. Professor Damien Batstone said bagasse and other agricultural residues were an abundant resource that could generate "green? or carbon-negative hydrogen at scale.
Chemistry - Computer Science - 19.10.2020
Ulissi and Facebook AI Create World’s Largest Catalysis Dataset
For decades, the push toward renewable energy sources like solar and wind has necessitated the development of countless technologies. From generation techniques, to power grid infrastructure and storage methods, renewable power development requires innovation from all angles. Today, thanks to the tireless work of researchers and engineers all over the world, methods for generating renewable energy have come a long way.
Chemistry - Physics - 15.10.2020
Small molecule is the key to HIV forming capsules
A group of University of Chicago scientists announced a groundbreaking study that explores the role of a small molecule, called IP6, in building the HIV-1 virus capsid. The genetic information of the HIV virus is surrounded by a layer of proteins called a capsid, which works as the armor of the virus.
Materials Science - Chemistry - 15.10.2020
A new approach boosts lithium-ion battery efficiency and puts out fires, too
Menlo Park, Calif . In an entirely new approach to making lithium-ion batteries lighter, safer and more efficient, scientists at Stanford University and the Department of Energy's SLAC National Accelerator Laboratory have reengineered one of the heaviest battery components - sheets of copper or aluminum foil known as current collectors - so they weigh 80% less and immediately quench any fires that flare up.
Chemistry - Environment - 13.10.2020
Researchers achieve breakthrough in production of ammonia without CO2 emissions
KU Leuven and the University of Antwerp join forces for sustainable ammonia synthesis. The production of ammonia - a very important chemical building block as part of synthetic fertilisers, among other things - is one of the main sources of CO2 emissions. By combining two different technologies, researchers from KU Leuven and the University of Antwerp have now discovered a CO2-free alternative.
Chemistry - Physics - 13.10.2020
Turning plastic waste into hydrogen and high-value carbons
The ever-increasing production and use of plastics over the last half century has created a huge environmental problem for the world. Currently, most of the 4.9 billion tonnes of plastics ever produced will end up in landfills or the natural environment, and this number is expected to increase to around 12 billion tonnes by 2050.
Environment - Chemistry - 13.10.2020

The production of ammonia - a very important chemical building block as part of synthetic fertilisers, among other things - is one of the main sources of CO2 emissions. By combining two different technologies, researchers from KU Leuven and the University of Antwerp have now discovered a CO2-free alternative.
Chemistry - Environment - 13.10.2020

Scientists have developed a new approach to stabilizing clay soils. The method involves using a battery-like system to apply electric current to carbonate and calcium ions in order to promote soil consolidation. Their findings were published yesterday in Scientific Reports. According to figures released by the UN yesterday, natural disasters have killed more than 1.2 million people since 2000 and cost nearly $ 3 trillion.These pressing threats bring into sharp focus the need for new answers to the problem of soil stabilization.
Environment - Chemistry - 12.10.2020
Making Heads or Tails Out of Phospholipid Synthesis
Breakthrough research adds to the understanding of creating lipids in artificial cells and of the origins and evolution of cellular membranes Luping Liu, from the Devaraj Research Group at UC San Diego, holds a sample of water from a natural alkaline source—Mono Lake, California. Photo courtesy of Luping Liu.
Health - Chemistry - 08.10.2020
UCLA Health scientists pioneer faster, cheaper COVID-19 testing
Unsplash/Mufid Majnun The new testing method was developed collaboratively by UCLA researchers and a startup company founded at UCLA. will soon be using a new coronavirus testing technology capable of assessing thousands of individual samples for COVID-19 simultaneously and producing accurate results in 12 to 24 hours.
Chemistry - Life Sciences - 08.10.2020

Intestinal organoids recapitulate not only the structure of intestinal epithelium but also its ability to regenerate following damage. Using this research tool, the group of Prisca Liberali unraveled mechanisms orchestrating organoid formation and intestinal regeneration with a unique image-based screening approach.
Materials Science - Chemistry - 08.10.2020

Manufacturing safer, more powerful batteries that use geopolitically stable resources requires solid electrolytes and replacing lithium with sodium. A chemical solution is now being offered to battery developers. The lithium batteries that power our electronic devices and electric vehicles have a number of drawbacks.
Health - Chemistry - 07.10.2020
First detailed look at how a molecular Ferris wheel delivers protons to cellular factories
No human cell can function without these tiny machines, which cause disease when they go haywire and offer potential targets for therapeutic drugs. All cells with nuclei, from yeast to humans, are organized like cities, with a variety of small compartments - organelles - that serve as factories where various types of work are done.
Materials Science - Chemistry - 07.10.2020

By Susanne Eigner Similar to batteries, supercapacitors are suitable for the repeated storage of electrical energy. TU Graz researchers have presented a particularly safe and sustainable variant of such a supercapacitor in Nature Communications. Additional at the end of the text Limited safety, sustainability and recyclability are key drawbacks of today's lithium-ion battery technology, along with restricted availability of starting materials (e.g.
Life Sciences - Chemistry - 07.10.2020
Jennifer Doudna Wins 2020 Nobel Prize in Chemistry
B iochemist Jennifer Doudna , a professor at UC Berkeley and faculty scientist at the Department of Energy's Lawrence Berkeley National Laboratory (Berkeley Lab), is co-winner of the 2020 Nobel Prize in chemistry for "the development of a method for genome editing." She shares the Nobel Prize with co-discoverer Emmanuelle Charpentier, who currently serves as the scientific and managing director of the Max Planck Unit for the Science of Pathogens in Berlin.
Life Sciences - Chemistry - 05.10.2020
By Susanne Eigner Researchers from TU Graz and Ruhr University Bochum show in the journal ACS Catalysis how the catalytic activity of cyanobacteria, also known as blue-green algae, can be significantly increased. This brings biotechnological and thus eco-friendly application a big step closer. Cyanobacteria, despite staining water green through their special pigments, are colloquially known as "blue-green algae", and convert light energy into chemical energy particularly effectively thanks to their highly active photosynthetic cells.
Chemistry - Materials Science - 01.10.2020

Researchers have successfully overcome a limiting problem with stabilizing the best-performing formulation of metal-halide perovskite films, a key player in a range of applications, including solar cells. Perovskites are a class of materials made up of organic materials bound to a metal. Their fascinating structure and properties have propelled perovskites into the forefront of materials' research, where they are studied for use in a wide range of applications.
Chemistry - Computer Science - 01.10.2020
’Digital chemistry’ breakthrough turns words into molecules
A new system capable of automatically turning words into molecules on demand will open up the digitisation of chemistry, scientists say. Researchers from the University of Glasgow's School of Chemistry, who developed the system, claim it will lead to the creation of a 'Spotify for chemistry' - a vast online repository of downloadable recipes for important molecules including drugs.
Health - Chemistry - 30.09.2020
Can organic plant protection products damage crops?
Researchers at Göttingen University discover new disease affecting maize Protecting crops against pests and diseases is essential to ensure a secure food supply. Around 95 percent of food comes from conventional agriculture, which uses chemical pesticides to keep crops healthy. Increasingly, however, organic pesticides are also being sought as an alternative.
Physics - Chemistry - 30.09.2020
Scientists Capture Candid Snapshots of Electrons Harvesting Light at the Atomic Scale
Berkeley Lab scientists gain insight into charge generation induced by light; could enable the design of better solar fuels devices In the search for clean energy alternatives to fossil fuels, one promising solution relies on photoelectrochemical (PEC) cells - water-splitting, artificial-photosynthesis devices that turn sunlight and water into solar fuels such as hydrogen.
Art & Design - Today
New special exhibition at the Josephinum is dedicated to Austria's exceptional artist Gustav Klimt
New special exhibition at the Josephinum is dedicated to Austria's exceptional artist Gustav Klimt

Health - Today
University of Manchester supports landmark Russell Group commitment to build healthier communities
University of Manchester supports landmark Russell Group commitment to build healthier communities

Health - Today
Cortical thickness, schizophrenia, and causality in psychiatry: when the trace is mistaken for the cause
Cortical thickness, schizophrenia, and causality in psychiatry: when the trace is mistaken for the cause
Career - Today
Low-income students and girls are steered away from 'risky' creative careers at school
Low-income students and girls are steered away from 'risky' creative careers at school

Environment - Today
UCalgary expedition, with NASA, Canadian and European space agencies, sets out to better understand state of Arctic ice
UCalgary expedition, with NASA, Canadian and European space agencies, sets out to better understand state of Arctic ice

Social Sciences - Mar 24
Young people's wellbeing is improving in Greater Manchester, major survey finds
Young people's wellbeing is improving in Greater Manchester, major survey finds
Environment - Mar 24
Australia's environment is improving but climate change is 'accelerating' damage to ecosystems and wildlife
Australia's environment is improving but climate change is 'accelerating' damage to ecosystems and wildlife














